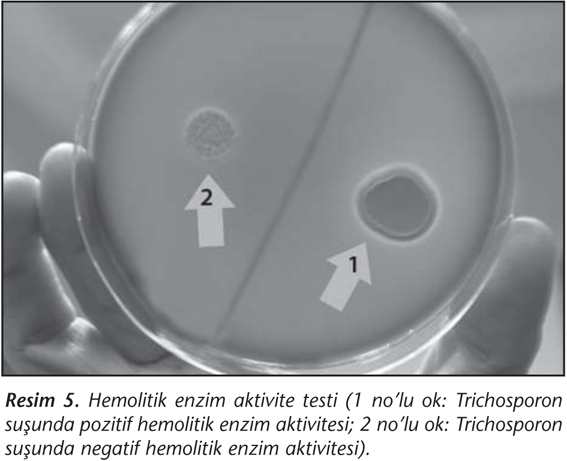

tavşan plazması


yazdir ozgun calisma original article mikrobiyol bul 2014 48 4 628 638 trichosporon spp suslarinda bazi virulans faktorlerin arastirilmasi investigation of some virulence factors in trichosporon spp strains feyza demir1 semra kustimur2 1 van

production of apolipoprotein c iii knockout rabbits using zinc finger nucleases protocol translated to turkish
yazdir ozgun calisma original article mikrobiyol bul 2014 48 4 628 638 trichosporon spp suslarinda bazi virulans faktorlerin arastirilmasi investigation of some virulence factors in trichosporon spp strains feyza demir1 semra kustimur2 1 van























































